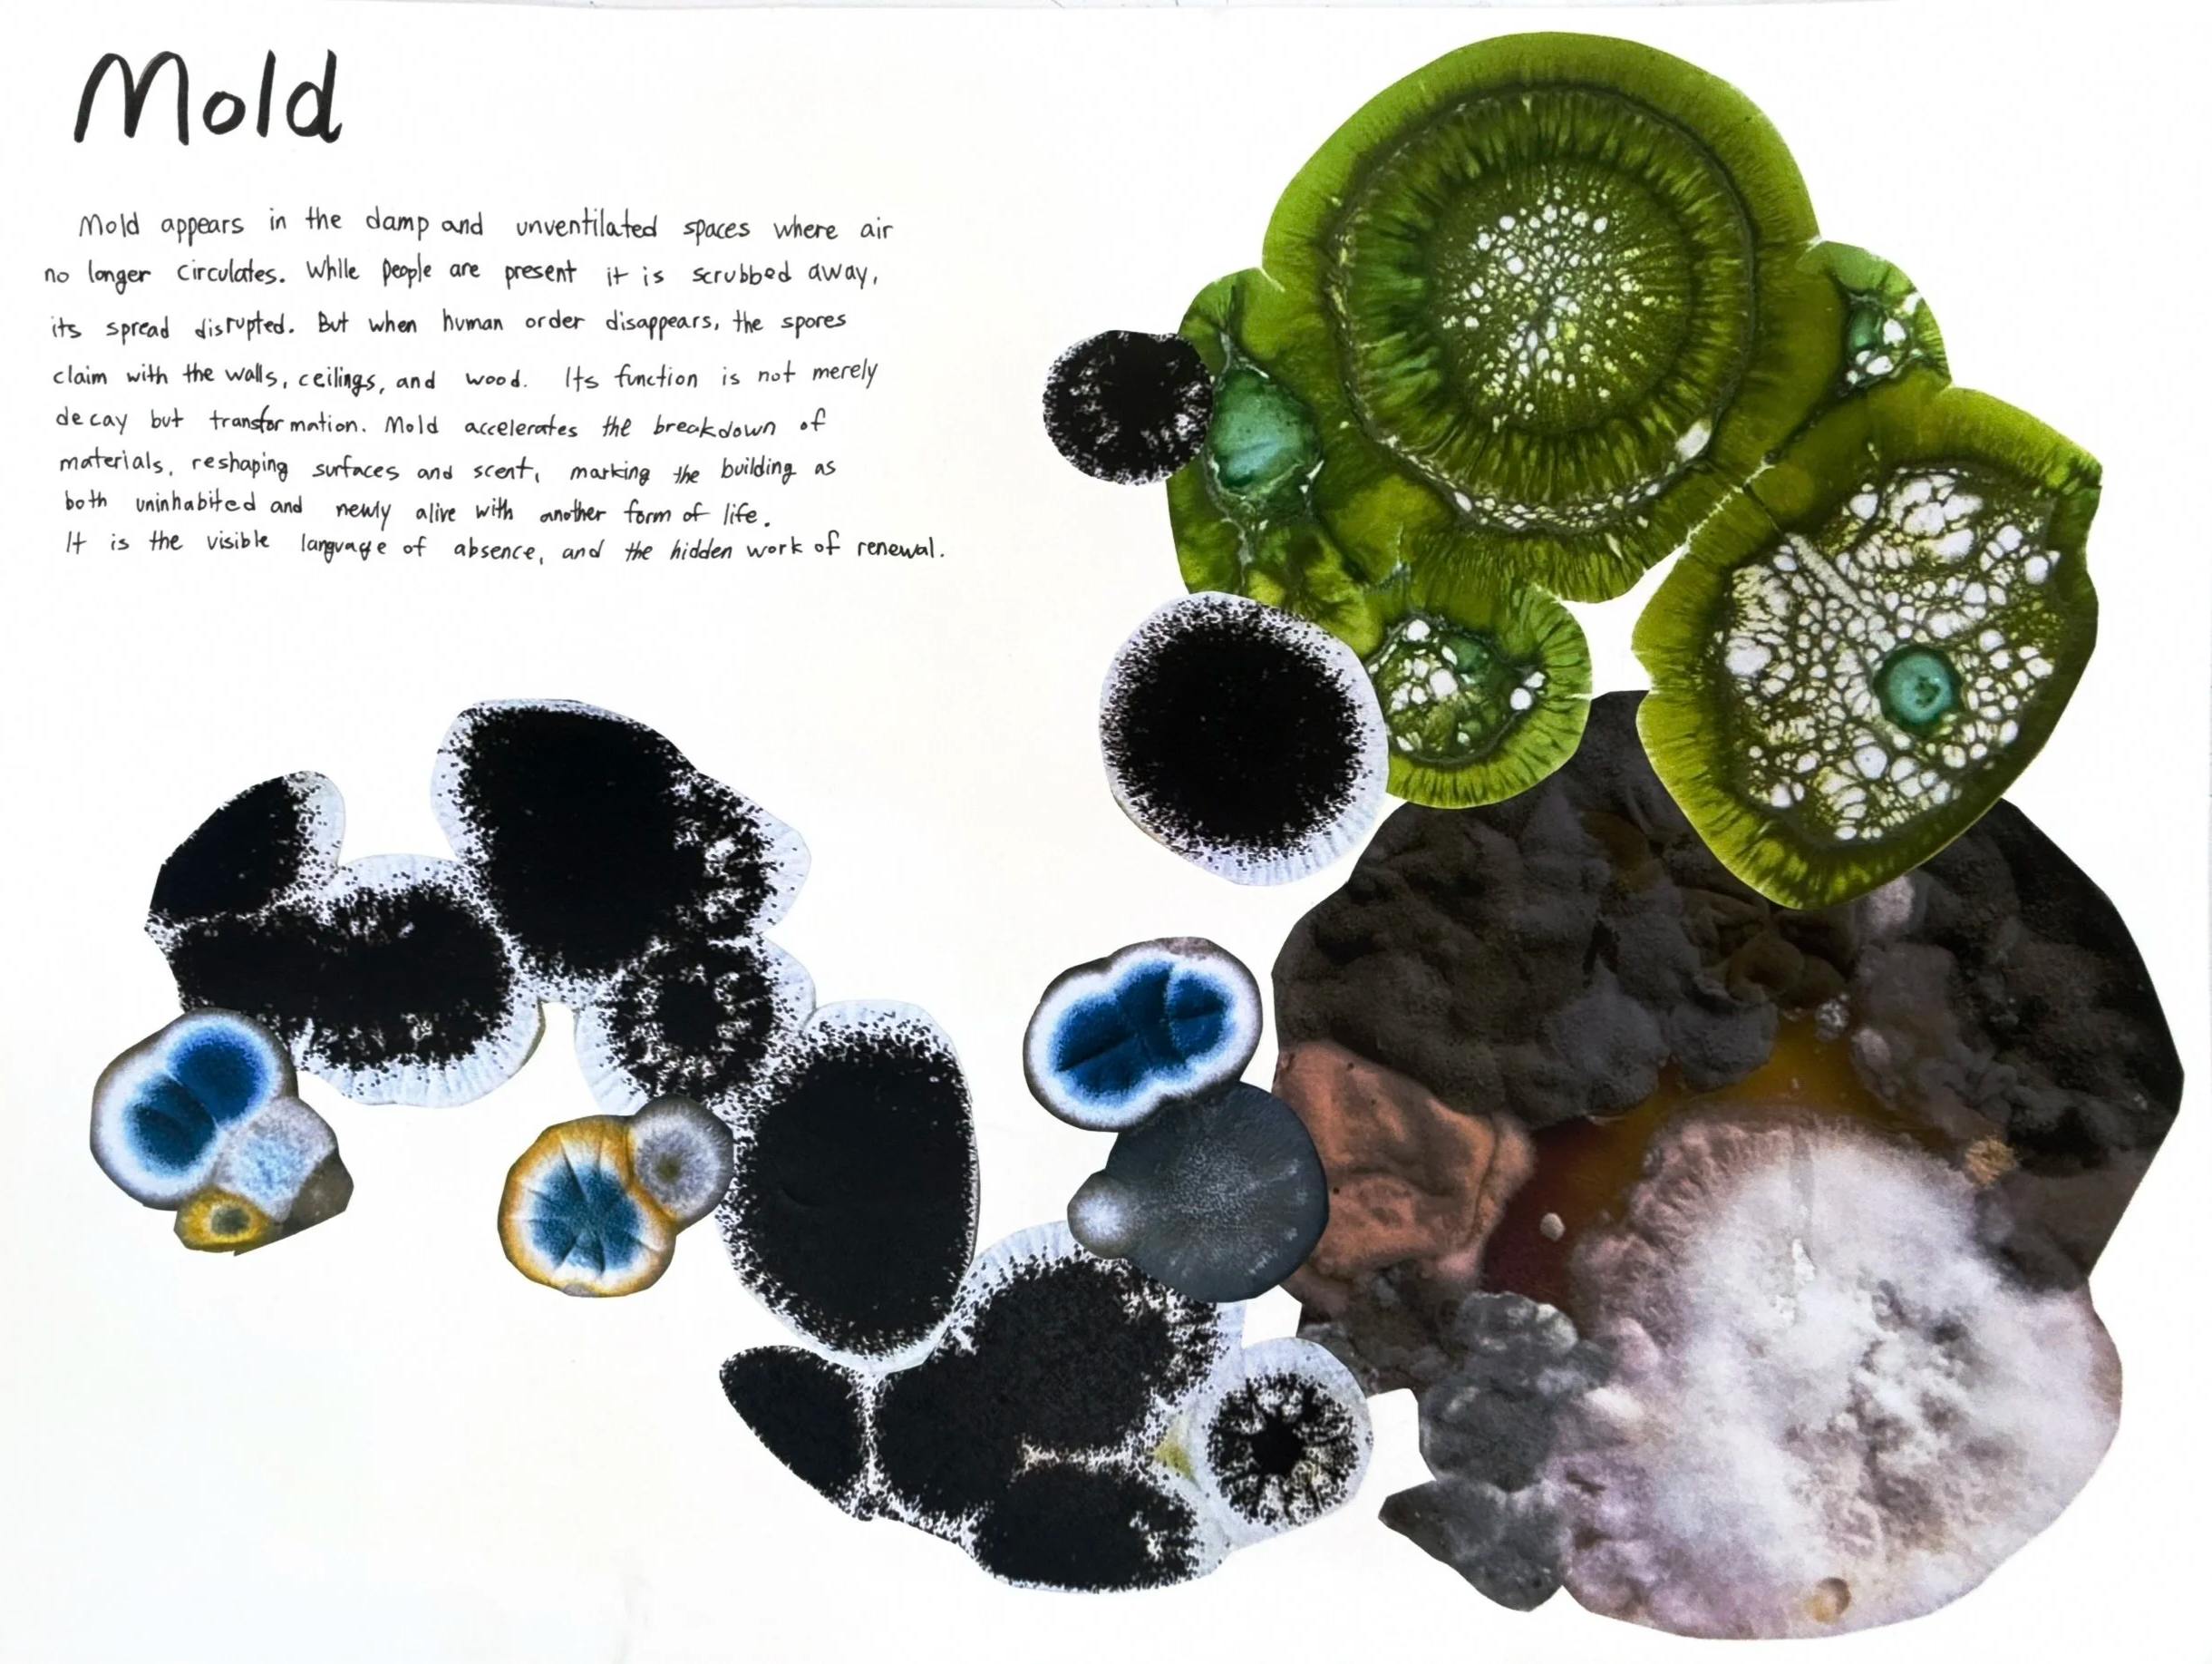
IMG_9444.png

Facing Up (2025)
A memorial architecture transforming Seongsu Bridge from a passage into a place of remembrance, confronting the forgotten tragedy of the 1994 collapse through light, shadow, and movement.











































































































A memorial architecture transforming Seongsu Bridge from a passage into a place of remembrance, confronting the forgotten tragedy of the 1994 collapse through light, shadow, and movement.